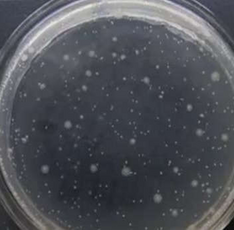
Normales Glas Normales Glas

Perfekte Balance zwischen Helligkeit und Dunkelheit – Mini-LED macht’s möglich
Ein Mini LED TFT nutzt tausende präzise steuerbare Leuchtzonen, um außergewöhnlich hohen Kontrast und tiefes Schwarz zu erzeugen. Durch die sehr gleichmäßige Hintergrundbeleuchtung erreicht es eine beeindruckende Helligkeit und hohe Bildhomogenität, selbst unter anspruchsvollen Lichtverhältnissen. Dadurch wirken Farben klarer, Details schärfer und das gesamte Bild deutlich realistischer.
Auf einen Blick:
LED-Chips dicht über die gesamte Hintergrundbeleuchtungsleiterplatte verteilt
Jeder LED-Chip einzeln ein-/ausschaltbar (Local Dimming)
Höherer Kontrast, höhere Helligkeit und größerer Farbraum
Geringerer Energieverbrauch


Mini LED Backlight
Local dimming
Contrast High
Pure Color
Herkömmliches Backlight
All backlight dice on
Contrast low
Not pure color
Mini-LEDs sind deutlich kleiner (Mini LED Dice size: 0.1...0.3 mm) als klassische LEDs. Dadurch können hunderte bis tausende einzelne Lichtzonen angesteuert werden. Dieses sogenannte Local Dimming ermöglicht:
Extrem hohen Kontrast: Helle Bildbereiche leuchten kräftig, während dunkle Bereiche tiefschwarz bleiben.
Satte, reine Farben: Durch die präzise Lichtsteuerung wirken Farben intensiver und klarer.
Verbesserte Bildtiefe: Details in Schatten und Highlights werden klarer herausgearbeitet.
Bei herkömmlichen LED-Backlights (Herkömmliches LED Dice Size: >= 2.5 mm) leuchten alle LEDs gleichzeitig. Eine zonenbasierte Steuerung ist nicht möglich. Die Folgen:
Niedriger Kontrast: Schwarze Bildbereiche erscheinen eher grau, helle Bereiche können überstrahlen.
Farben weniger intensiv: Durch den fehlenden Lichtfokus wirken Farben weniger präzise.
Geringerer Dynamikumfang: Feinste Helligkeitsunterschiede gehen oft verloren.

Für weitere Informationen: Zum Kontakt

Neuer Maßstab für farbige E-Paper-Displays: Perfekte Performance in 10.3 Zoll Grösse!
Farbige E-Paper-Displays, die Videos wiedergeben können, kombinieren innovative Materialwissenschaft mit cleverer Elektronik und Optimierungsstrategien. Unser neues E-Paper-Display vereint bahnbrechende Technologie mit erstklassigem Design: Mit einer Farbdarstellung von 4096 Farben und einer Bildwiederholrate von beeindruckenden 60 Bildern pro Sekunde setzt es neue Maßstäbe. Somit können auf diesem Display nicht nur Standbilder sondern auch kurze Filme angezeigt werden. Auf einer Diagonale von 10.3 Zoll bietet das Display eine Auflösung von 1120 x 840 quadratischen Farb-Pixeln – für gestochen scharfe und lebendige Darstellungen. Die großzügige Active Area von 209.664 x 157.248 mm sorgt für optimale Nutzbarkeit bei minimalem Platzbedarf.
Dank des Intel80 MCU-Interfaces lässt sich das Display nahtlos in Ihre Anwendungen integrieren und überzeugt durch seine Vielseitigkeit in Anzeigen- und Bedienlösungen. Mit einer Gesamtgröße inklusive Glasbackplane von 216.7 x 174.4 x 0.8 mm ist es nicht nur leistungsstark, sondern auch extrem flach und leicht. Ideal für moderne Designs, dynamische Präsentationen, interaktive Bedienfelder oder innovative Werbedisplays.
Bringen Sie Ihre Projekte auf das nächste Level – mit einem E-Paper-Display, das Design und Technik perfekt vereint. Entdecken Sie die Zukunft der Anzeige- und Bedienlösungen!
- Farb E-Paper mit 4096 Farben und einer Auflösung von 1120 x 840 Pixels
- Schnelle Reaktionszeit für 60 Bilder pro Sekunde
- Breiter Betrachtungswinkel und hoher Kontrast
- Betriebstemperatur 0 ... 50°C
- Verfügbar im Quer- und Hochformat
Für weitere Informationen: Zum Kontakt


Entdecken Sie unsere TFT-Touch-Displays mit USB-C Interface – vielseitig, modern und leistungsstark!
Der USB-C Connector bietet die Möglichkeit die Signale von Display, Touch und Stromversorgung über ein Kabel zu transportieren und so die Einheit auf einfache Art zu betreiben. Ein zusätzlicher Backup-Stromeingang über Micro-USB garantiert maximale Flexibilität. Mit 2.4 bis 10.1 Zoll werden kleine bis mittlere Grössen abgedeckt. Die IPS-TFT-Displays liefern gestochen scharfe Bilder, hohen Kontrast und maximalen Betrachtungswinkel aus allen Richtungen. Der kapazitive Multi-Touch sorgt für eine einfache und präzise Steuerung, während die optische Bonding-Technologie Reflexionen minimiert und die Bildqualität verbessert. Jedes Modell verfügt über eine robuste, einfarbig bedruckte Standard-Coverlens, die eine hohe Widerstandsfähigkeit gewährleistet. Selbstverständlich können kundenspezifische Anpassungen an der Coverlens vorgenommen werden.
Kompatibel mit Windows-, Android- und Linux-Systemen, sind die Displays die ideale Wahl für industrielle, kommerzielle und kreative Anwendungen. Kombinieren Sie modernes Design mit einfacher Integration – und bringen Sie Ihre Projekte auf ein neues Level!


- USB-C interface - nur eine Schnittstelle für alles
- IPS TFT mit kapazitivem Touch in diversen Grössen
- Bestmögliche Bildqualität durch Verwendung von IPS TFT in Kombination mit Optischem Bonden
- Coverlens kann kundenspezifisch angepasst werden
Für weitere Informationen: Zum Kontakt




Entdecken Sie die Welt des Internet of Things (IoT) mit Marelcom AG, Ihrem vertrauensvollen Partner für innovative Lösungen. Unsere maßgeschneiderten IoT-Lösungen ermöglichen Ihnen eine effiziente Steuerung und Überwachung Ihrer Umgebung. Von Smart-Home-Anwendungen bis hin zur industriellen IoT-Optimierung stehen wir Ihnen zur Seite, um Ihr Projekt erfolgreich umzusetzen. Lassen Sie uns gemeinsam die Zukunft gestalten und die Möglichkeiten von IoT mit Marelcom AG erkunden!
Kontaktieren Sie uns noch heute!
Um die Statistikdaten eines Geräts auszulesen, stehen folgende Möglichkeiten zur Verfügung:
1. Das Gerät muss geöffnet werden und über den Servicestecker mit einem PC verbunden werden.
2. Alternativ können die Daten über das vorhandene Display eingesehen werden.
In beiden Fällen ist eine physische Präsenz vor Ort erforderlich. Um dies zu umgehen, kann das Gerät mit dem Internet verbunden werden.
Im Gerät wird ein WiFi Modul benötigt.
Für die Übertragung der gewünschten Daten an das WiFi-Modul und deren Bereitstellung über einen Webserver oder die Weiterleitung an einen spezifischen Webserver wird eine zusätzliche Software benötigt.

Die Daten können entweder vor Ort drahtlos vom Gerät ausgelesen und manipuliert werden, oder das Gerät kann mit dem Internet verbunden werden, um die Daten in eine Cloud zu senden. Auf diese Weise hat der Hersteller die Daten in Echtzeit zur Verfügung.
Zusätzlich kann eine drahtlose Aktualisierung der Firmware durchgeführt werden.
Wenn das Gerät über das Internet erreichbar ist, muss sichergestellt werden, dass es keine Sicherheitslücke für das gesamte lokale Netzwerk darstellt.
Sollte das Gerät eine Sicherheitslücke aufweisen, könnte ein Angreifer über dieses Gerät auf das lokale Netzwerk und die darin befindlichen Geräte zugreifen. Dies muss in jedem Fall verhindert werden.
WiFi Modul
Es ist erforderlich, den Datenaustausch zwischen dem Mikrocontroller (uP) und dem WiFi-Modul zu implementieren. Der damit verbundene Aufwand variiert je nach Anzahl und Art der zu übertragenden Daten von gering bis erheblich.
Erstellung einer Website zur Darstellung der Daten:
Variante 1:
Konfiguration eines Webservers
Variante 2:
Implementierung von Datenverschlüsselung
Konfiguration einer Cloud
Übertragung der Daten an die Cloud.


TFT-Display im Holzlook?
Ja das ist möglich. Marelcom AG bietet Ihnen diesen speziellen Look für kundenspezifische Lösungen an. Ein cooler Effekt, der die Holzmaserung täuschend echt nachbildet. In ausgeschaltetem Zustand bleibt nur die Holzstruktuer sichtbar und sobald das Display eingaschltet wird verschwindet der Holzeffekt im angezeigten Bereich.
Dieser Effekt kann für jede beliebige TFT-Grösse zum Einsatz kommen. Die Struktur ist in der von Ihnen gewünschten Farbe möglich. Eine Kombination mit einem kapazitiven Touch oder einer spezielle Form der Cover Lens - fast alles ist realisierbar.
Sind Sie interessiert and weiteren Informationen?
Zögern Sie nicht, uns via Mail oder Telefon zu kontaktieren.

Eine geeignete Anwendung von runden TFT Displays ist die Kombination mit Encoder. Marelcom AG hat in Ihrem Sortiment 3 unterschiedliche Grössen.
Die Einheit ist eine geschlossene Lösung, das die Anzeige, den Encoder, die Taste und die Status-LED perfekt in einer Drehknopfanzeige kombiniert. Die einzigartige innovative Struktur und der exquisite Herstellungsprozess des Moduls sorgen für eine ausgezeichnete Zuverlässigkeit und ein hervorragendes Steuerungserlebnis. Die Einheit eignet sich als Drehknopfsteuerung in vielen industriellen Anwendungen von elektronischen Produkten.
Mögliche Grössen:
1.3" IPS TFT mit Push-Schalter, integriertem Encoder und LED Indicator
2.1" IPS TFT mit Push-Schalter, integriertem Encoder und LED indicator
2.5" IPS TFT mit Push-Schalter, integriertem Encoder und LED indicator
Alle 3 Einheiten sind gleich aufgbaut und haben die gleiche Schnittstelle. Das IPS TFT wird über eine serielle Schnittstelle angesteuert. Für die Status LED wurde eine RGB LED Beleuchtung gewählt. Die Farbe der Status LED Beleuchtung kann somit frei gewählt werden. Encoder, Push-Schalter und LED Beleuchtung werden separat angesteuert. Die komplette Einheit wird über ein 10 Pin Standard FPC Connector mit einem Raster von 0.5 mm angeschlossen, egal welche Einheit Sie wählen.
Optional kann die Einheit auch mit einem kapazitiven Touch ausgestattet werden.
Weitere Details können Sie gerne in der Spezifikation einsehen, welche Sie mittels Klick auf den gewünschten Typen herunterladen können oder Sie kontatieren uns per Mail oder Tel.

Wir präsentieren Ihnen unsere neue Webseite. Durchstöbern Sie unsere Seiten und verschaffen Sie sich einen Überblick über uns, unsere Produkte und unsere Entwicklungsleistungen. Navigieren Sie mit Hilfe des Menu und steigen Sie direkt über den gewünschten Themenbereich ein!
Eine elegante Glas-Oberfläche für TFT-Einheiten, egal ob das Display ein- oder ausgeschaltet ist!
Normalerweise wird die Coverlens mit einem transparenten OCA vollflächig mit dem kapazitiven Touchsensor verbunden. Die TFT Active Area bleibt bei ausgeschaltetem Zustand je nach Typ des Displays und der verwendeten Polarizer mehr oder weniger stark sichtbar. Um diesen Effekt zu eliminieren und eine elegante Oberfläche auch im ausgeschalteten Zustand zu erreichen, kommt das Dark Bonding zum Einsatz.
Bei Verwendung eines Dark OCA erreichen wir eine komplett schwarze Oberfläche bei ausgeschaltetem Zustand. D.h. der Bereich der TFT Active Area ist bei ausgeschaltetem Zustand nicht mehr sichtbar.
Sie sind interessiert an einer Dark-Bonding Lösung? Kontaktieren Sie uns einfach per Mail oder Telefon. Gerne führen wir Ihnen den Verschwinde-Effekt auch bei Ihnen vor Ort vor.

An unsere geschätzten Kunden
Seit dem Ausbruch der Corona – Pandemie im letzten Frühling, sind wir ja bereits von einer deutlichen Schwächung der Logistikkette aus Fernost betroffen. Massiv höhere Logistikkosten und deutlich längere Laufzeiten sind seither die direkte Folge daraus. Darüber hinaus sind wir aber mehr und mehr mit einer deutlich spürbaren Versorgungskrise in weiten Bereichen unserer Wirtschaft konfrontiert. So werden wir aktuell gerade von einer umfassenden Verknappung im Halbleiterbereich überrollt. Auch einfache Controller sind zur Zeit nur noch schwer beschaffbar, die Preise vervielfachen sich und erreichen schwindelerregende Höhen. Die Lieferzeiten tendieren bei vielen Herstellern gegen 40 Wochen und mehr!
Zusätzlich ist auch der Markt für Display-Gläser betroffen und auch hier verknappt sich das Angebot laufend. In den letzten Wochen sind auch hier die Preise und Lieferzeiten spürbar angestiegen.
Kunststoffgranulate für Spritzgussprodukte sind seit diesem Jahr massiv teurer geworden. Es kommt aber auch zu Verknappungen und sehr langen Lieferzeiten in diesem Bereich für gewisse Kunststoffe.
Auf Grund dieser Situation raten wir Ihnen dringend Ihren zukünftigen Bedarf, auch fürs nächste Jahr, zu ermitteln und frühzeitig zu disponieren. Bitte fragen Sie die Produkte zeitnah bei uns an und gehen Sie nicht davon aus, dass die letztjährigen Preise noch Gültigkeit haben. Die Gefahr einer Versorgungslücke ist nun mehr als greifbar.
Wir gehen davon aus, dass diese Krise noch dieses Jahr anhalten wird und sich im Laufe der nächsten Wochen und Monate weiter zuspitzt.
Gerne stehen wir Ihnen für weitere Auskünfte zur Verfügung und danken Ihnen für Ihr vorausschauendes Handeln.
Mit freundlichen Grüssen
Marelcom AG
Hans-Jörg Marti Hansruedi Freuler
CEO CFO/CLO

Es gibt unzählige Anwendungen wo keimfreie Oberflächen den Alltag erleichtern. Sei es in der Medizin, Lebensmittelindustrie, im Detailhandel, in öffentlichen Gebäuden oder sogar in Kleidern. Mittlerweile sind viele Materialien mit antibakterieller Wirkung realisierbar. Displays und kapazitive Touchpanel mit einem antibakteriellen Frontglas bringen einen grossen Nutzen in Bezug auf Hygienevorschriften. Es ist ein Glas, welches zusätzliche antibakterielle (bakteriostatische und sterilisierende) Funktionen aufweist, wobei die ursprünglichen Funktionen und Eigenschaften des Glases erhalten bleiben. MARELCOM AG bietet die Möglichkeit an, Frontgläser mit antibakterieller Beschichtung herzustellen.

Silber wirkt nachweislich gegen Bakterien. Positiv geladene Silberionen adsorbieren negativ geladene Bakterien und stören dadurch das bakterielle Ladungsgleichgewicht. Silberionen können leicht in die Bakterien eindringen und beeinträchtigen die Atmung und Vermehrung der Bakterien. Sie können das Wachstum von Bakterien hemmen, Proteasen der Bakterien adsorbieren und schnell verbinden, um sie zu zerstören, wodurch die Bakterien inaktiv werden.

Der Beschichtungsprozess von antibakteriellem Glas ist relativ einfach. Die Beschichtung kann grundsätzlich auf verschiedensten Materialien vorgenommen werden. Beim Werkstoff Glas spielt die Art des Glases, Dicke, Länge und Breite keine entscheidende Rolle.
Das antibakterielle Glas kann chemisch oder physikalisch vorgespannt werden, und die Vorspannleistung entspricht dem Standardwert von nicht antibakteriellem Glas.
Durch die anschließende Aufbringung von AF kann die Doppelfunktion von antibakteriellem und Anti-Fingerprint auf der Glasoberfläche realisiert werden, wobei sich die Funktionen gegenseitig nicht benachteiligen.
Eine Kombination mit AR Antireflexion Glas oder AG Antiglare Glas ist ebenfalls möglich.